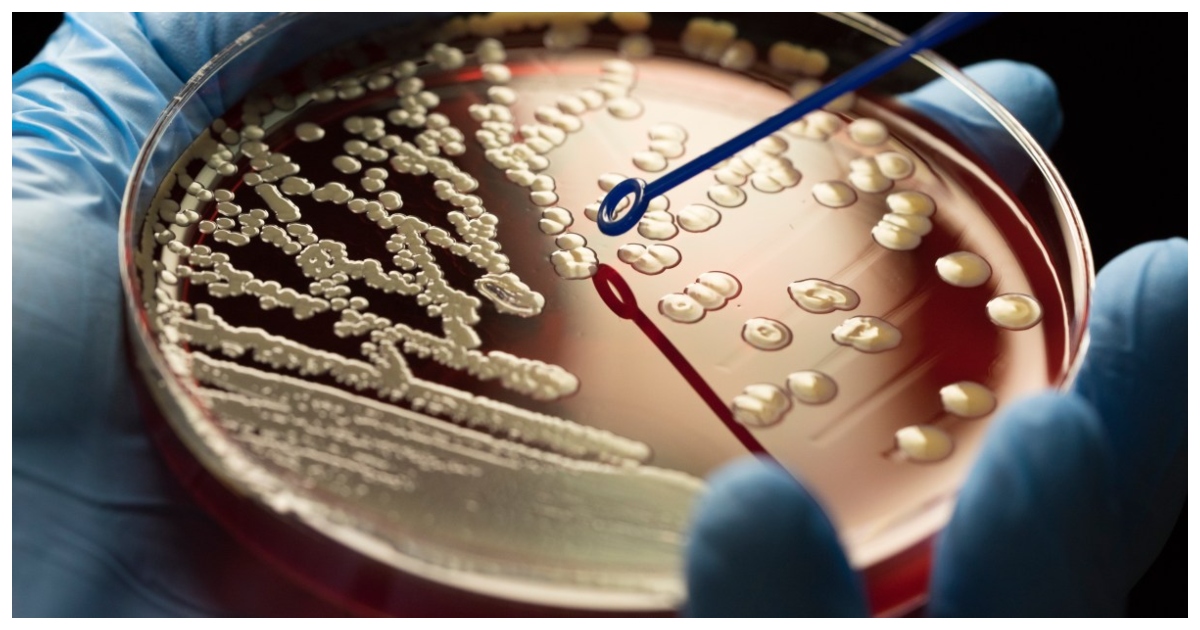
অ্যামেরিকায়ও ক্রমেই বাড়ছে সুপারবাগ সংক্রমণ। ছবি: দ্য টাইমস

উদ্বেগজনক হারে বাড়ছে সুপারবাগ সংক্রমণ, ঝুঁকিতে ফিটনেসপ্রেমীরা

টিবিএন ডেস্ক
প্রকাশিত: আগস্ট ১৭ ২০২৫, ৬:০৬ হালনাগাদ: ডিসেম্বর ৩ ২০২৫, ১৫:৫০
অ্যামেরিকায়ও ক্রমেই বাড়ছে সুপারবাগ সংক্রমণ। ছবি: দ্য টাইমস
- 0
হাসপাতালের বাইরে যেসব তরুণরা এই রোগে আক্রান্ত হন তারা প্রায়শই ক্রীড়া দল বা জিম ব্যবহারকারী হয়ে থাকেন।
সম্প্রতি ব্রিটেনের হেলথ সেইফটি সংস্থার (ইউকেএইচএসএ) একটি প্রতিবেদনে এমআরএসএ সুপারবাগ সংক্রমণ বৃদ্ধির বিষয়ে উদ্বেগ প্রকাশ করা হয়েছে। প্রতিবেদনে বলা হয়েছে, স্থানীয় কমিউনিটির মধ্যে বিশেষ করে জিম ও হেলথ ক্লাবগুলোতে উদ্বেগজনক হারে বাড়ছে সুপারবাগ সংক্রমণ।
দ্য টাইমস জানায়, অ্যামেরিকায়ও ক্রমেই বাড়ছে সুপারবাগ সংক্রমণ। বিশেষজ্ঞরা সংক্রামিত ত্বক বা রক্তের সংস্পর্শে এসেছে এমন তোয়ালে বা রেজারের মতো ব্যক্তিগত জিনিসপত্র ভাগ করে নেওয়ার ক্ষেত্রে সতর্ক করেছেন।
মেথিসিলিন-প্রতিরোধী স্ট্যাফিলোকক্কাস অরিয়াস সংক্ষেপে এমআরএসএ হল এক ধরণের ব্যাকটেরিয়া যা বিভিন্ন অ্যান্টিবায়োটিকের বিরুদ্ধে প্রতিরোধ গড়ে তোলে। ফলে সংক্রমণের চিকিৎসা প্রক্রিয়াকে জটিল হয়ে পড়ে।
হাসপাতালের বাইরে এমআরএসএ’র ঘটনা ক্রমেই বাড়ছে। আর এসব এসব সংক্রমণের একটি গুরুত্বপূর্ণ উৎস হচ্ছে জিম । স্বাস্থ্য কর্মকর্তারা পরিস্থিতি নিবিড়ভাবে পর্যবেক্ষণ করছেন। ব্রিটেনে বাসিন্দাদের ব্যক্তিগত জিনিসপত্র ভাগাভাগি না করার জন্য অনুরোধ করা হচ্ছে।
সাধারণত এমআরএসএকে হাসপাতালের রোগজীবাণু হিসেবে বিবেচনা করা হত এবং শুধুমাত্র অসুস্থ ব্যক্তি, বৃদ্ধ ব্যক্তিরাই সংক্রমিত এতে হত। তবে সাম্প্রতিক ঘটনা বলছে ,এই ব্যাকটেরিয়া তরুণ এবং সুস্থ ব্যক্তিদের বেশি সংক্রমিত করছে ।
দ্য ইন্ডিপেন্ডেন্ট জানায়, ব্রিটেনের হাসপাতালের বাইরে মোট ১৭৫ জন সংক্রামিত হয়েছেন। যা ২০১৯ সালের একই সময়ের তুলনায় ৪৭ শতাংশ বেশি।
ত্বক থেকে ত্বকের সংস্পর্শে অথবা দূষিত সরঞ্জামের মাধ্যমে ব্যাকটেরিয়া ছড়িয়ে পড়তে পারে। স্বাস্থ্যবিধি মেনে চলায় অবহেলা যেমন জিমের সরঞ্জাম পরিষ্কার না করা বা ওয়ার্কআউটের পরে গোসল না করা, সংক্রমণের ঝুঁকি বাড়িয়ে তুলতে পারে।
গত মাসে প্রকাশিত ইউকেএইচএসএ’র তথ্য বলছে, ২০২৫ সালের প্রথম তিন মাসে সংক্রমণের হার গত বছরের একই সময়ের তুলনায় ৪ দশমিক ১ শতাংশ বৃদ্ধি পেয়েছে। এদিকে, ২০১৯ সালের একই প্রান্তিকের তুলনায় বৃদ্ধি পেয়েছে ৩৯ দশমিক ৪ শতাংশ ।
ইম্পেরিয়াল কলেজ লন্ডনের আণবিক জীববিজ্ঞানের সহযোগী অধ্যাপক অ্যান্ড্রু এডওয়ার্ডসের মতে, হাসপাতালের বাইরে যেসব তরুণরা এই রোগে আক্রান্ত হন তারা প্রায়শই ক্রীড়া দল বা জিম ব্যবহারকারী হন।
অ্যামেরিকার রিডিং ইউনিভার্সিটির সাইমন ক্লার্ক বলেন, ‘সংক্রমণ বেড়েই চলেছে কিন্তু বিস্ফোরিত হচ্ছে না।’ তিনি জানান, এই ব্যাকটেরিয়াটি বিবর্তিত হয়েছে। এতে কোন সন্দেহ নেই।
এই বছরের শুরুর দিকে, গ্রীষ্মে জিম এবং পোশাক পরিবর্তন রুমে এমআরএসএ ছড়িয়ে পড়ার বিষয়ে অ্যামেরিকায় সতর্কতা জারি করা হয়।
ইউএস সেন্টার ফর ডিজিজ কন্ট্রোল অ্যান্ড প্রিভেনশনের (সিডিসি) কর্মকর্তারা বলেছেন, এমআরএসএ অ্যাথলেটিক সুবিধা, লকার রুম, জিম এবং হেলথ ক্লাবগুলোতে দ্রুত ছড়িয়ে পড়ার কারণ জিমের সরঞ্জাম ভাগ করে নেওয়া হয় এবং ত্বক থেকে ত্বকের সংস্পর্শে আসা।